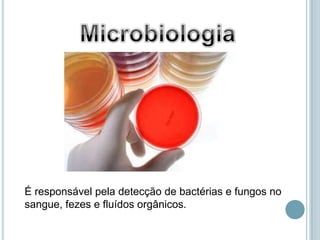
É responsável pela detecção de bactérias e fungos no
sangue, fezes e fluídos orgânicos.

O documento fornece uma introdução sobre análises clínicas, explicando que laboratórios de análises clínicas auxiliam médicos na detecção de doenças através de exames de amostras biológicas. Detalha os principais setores de laboratório e procedimentos de coleta de sangue, como uso de diferentes tubos contendo anticoagulantes e condições necessárias para a coleta.